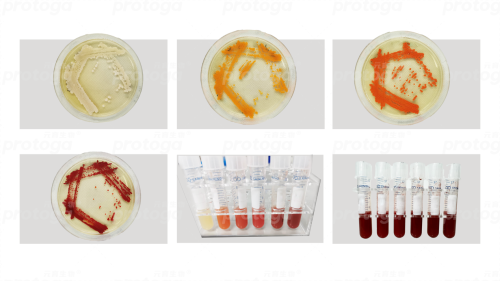

20个月,3大平台,300倍!元育生物以全左旋虾青素引领合成生物新纪元
- 网络
- 浏览
- 2024-12-31 00:08
元育生物发酵基地的车间内,一排5升的玻璃反应器里深红色的液体在有节奏地翻滚,相邻不远的区域,是更大的30升、50升、300升、500升直到3000L的不锈钢反应器按漂亮的梯度整齐排列,锃亮的罐体反射着金属的光泽。这些容器中承载着的不仅仅是普通的酵母菌株,而是通过尖端的基因编辑技术和精细的发酵工程精心培育的生命体。
这些小小的酵母细胞,即将成为改变农业食品领域游戏规则的关键——全左旋虾青素的高效生产者。

图1:元育发酵生产左旋虾秦素
技术创新:全左旋虾青素的合成生物学突破
在生物科技日新月异的今天,合成生物学作为一门新兴的交叉学科,正引领着生物制造领域的深刻变革。谈及全左旋虾青素的合成生物学研究,基因编辑与发酵工程无疑是两大核心“钥匙”,元育生物首席研究员屈玉娇如是说。
基因编辑技术能够为酵母细胞“安装”上全新的功能,通过增强某些基因的活性(基因过表达),或是移除那些不再需要的基因(基因敲除),以此赋予酵母新的生命力。解脂耶氏酵母,在自然状态下并不具备合成类胡萝卜素,尤其是虾青素的能力。然而,元育生物以基因编辑技术为突破口,成功解锁了酵母合成虾青素的奥秘,开启了生物制造领域的新篇章。
在探索酵母合成虾青素的道路上,元育生物的科研团队精心布局了三大策略。一是向酵母中引入微藻的虾青素代谢相关基因,为酵母构建了一条全新的代谢通路。通路的成功建立,标志着酵母从此拥有了合成虾青素的能力。二是增加代谢途径中关键酶的基因拷贝数,提升酶的表达水平,增强代谢流中关键中间体的供应,稳步提高虾青素的产量。三是调控各转化步骤中不同酶的使用比例,确保中间产物能够充分转化,避免资源浪费,进一步保证最终产物虾青素的高效转化。这三个策略为虾青素高产菌株的建立奠定了坚实的基础。
图2:元育生物生物合成虾青素菌株
发酵工程则是通过优化培养条件,如调整培养基配方、温度、pH值、氧气供应和底物浓度,以及改进发酵策略,以此提升酵母的生长速率和虾青素的产量。
元育生物在发酵工程领域的关键技术创新体现在以下方面。一是开发了与特定菌株完美匹配的发酵培养基及工艺,为酵母生长与虾青素合成提供了最优环境。二是实施两段式发酵策略,巧妙地区分了细胞增殖与产物累积两个阶段,有效减轻了产物对细胞生长的抑制作用,进一步推动了虾青素的高效生产。三是配合菌株的特性对酵母内部的代谢流程进行了精细的调整与优化,使得整个生产过程变得更加流畅且高效。
基因编辑与发酵工程的携手合作是发掘酵母生产虾青素的潜力的关键。通过基因编辑技术改良的酵母菌株给了发酵提高虾青素产量更多的可能性。同时,发酵过程中收集的数据可以用来进一步指导基因编辑策略,以实现更精细的代谢调控。
“两种技术的结合使用,让我们整个生产过程在高效与稳定之间找到了完美的平衡点。”元育生物首席生产工程师韩柱表示。
应用探索:全左旋虾青素在农业食品领域的变革力量
全左旋虾青素有着“超级抗氧化剂”的美誉,因其特定的立体化学结构而具备更优的生物活性和生物利用度,因此,其能够显著提升农业食品的品质与健康水平。
在水产饲料行业中,虾青素的添加不仅能增强水产动物的免疫力,还能提高其生长速度和存活率。以三文鱼为例,虾青素能够赋予三文鱼鲜艳的橙红色,提升其外观品质。虾青素极强的抗氧化能力有助于保持三文鱼的新鲜度和营养价值。虾青素可以提高鱼类的免疫力和成活率,对其正常生长和健康养殖及生长和繁殖具有重要作用。虾青素对三文鱼、虾、蟹等水产动物的生长和养殖过程具有多方面的积极作用。
以虾饲料为例,每吨饲料中通常会添加大约两公斤的虾青素,据此估算,仅这一项产品线每年就需要约一万六千吨的虾青素。然而,当前市场上实际使用的虾青素总量仅为所需量的八分之一,市场存在巨大的缺口和增长空间。
在食品添加剂领域,虾青素的应用也在不断扩展。作为一种天然色素,它不仅能为食品提供鲜艳的色泽,还能增强食品的营养价值。随着消费者对食品添加剂安全性和健康性的日益关注,虾青素作为一种天然、安全的替代品,其市场需求有望进一步增长。
在传统虾青素领域中,主要包括化学合成品以及通过红法夫酵母生产的右旋虾青素。然而,这两种形式的虾青素的生物活性极低。相比之下,元育生物研发的虾青素则具备极高生物活性,其活性与源自红球藻的左旋虾青素活性相当。
技术的进步为虾青素的生产提供了新的可能性,政策的支持更是推动虾青素市场发展的重要因素。当前,许多国家已经开始重视生物科技产业的发展,并出台了一系列扶持政策。

图3:与生物科技相关的国家政策(部分)
着眼未来,随着市场需求的增长、技术的进步以及政策的支持,全左旋虾青素有望在未来的市场中占据更大的份额,还能为农业和食品行业带来新的增长点,推动行业的可持续发展。
合成生物平台优势:元育生物的研发实力与产品特色
在探索自然界的奥秘与生命的奇迹中,元育生物以其卓越的技术与创新理念,在合成生物领域树立了新的标杆。
“全左旋结构、极高的纯净度、高虾青素含量以及高效的生产能力,构成了元育生物在虾青素领域的核心优势。”韩柱表示。
全左旋虾青素,这种特定构型的虾青素具有更高的生物利用度和更强的抗氧化能力,使其在行业饲料等领域展现出极高的应用价值。“我们始终致力于提供纯度与性价比更高的合成生物产品,这正是元育生物生产的全左旋虾青素带给客户的独特价值。”韩柱强调。
在纯净度方面,元育生物通过高效液相色谱(HPLC)技术严格监控,确保虾青素占总类胡萝卜素的比例达到高标准。“基于元育的三大合成生物技术平台,通过近20个月的不懈努力。当前,元育生物所生产的虾青素占总类胡萝卜素比例为82.9%(以峰面积计),全左旋虾青素占比93.4%。”这种对产品指标的极致追求要求,是企业对产品质量严苛要求的具体体现。特别值得一提的是,元育生物的产品中反式虾青素的比例高达93.3%,均显著超越行业平均水平。

图4:元育生物合成虾青素的HPLC峰图
在生产效率方面,元育生物同样表现非凡。传统的雨生红球藻生产左旋虾青素的产率为5-25 mg/L,元育生物利用酵母生产左旋虾青素的产率最高为3000 mg/L,这意味着左旋虾青素的生产效率提高了120至300倍。相比传统的左旋虾青素生产方式,元育生物的虾青素生产成本降低了一半以上,使得高品质虾青素更加“亲民”,也为市场带来了更具竞争力的产品选择。

图5:生物合成虾青素大型生产体系
每一次基因调整都是对未知领域的勇敢迈进,每一次参数调整都可能开启新的可能性。实验室里,微小的生命体们正展开一场意义深远的华丽蜕变,如同一直深耕在生物技术领域的元育生物一般,正迎来属于自己的创新变革。
本文地址:http://www.quanqiunongye.com/nytt/101.html
向新提质,向高跃升!天能携共赢商擎启2025!头条1
抹茶陈建:为了当世界抹茶之都,日本宇治茶商们都有多努力?头条2
2025年天能营销战略解读头条3- 头条赣南脐橙电商圆桌会议暨首届抖音直播大赛颁奖仪式举行
- 头条抹茶陈建:为了当世界抹茶之都,日本宇治茶商们都有多努力?
- 头条畅通产销渠道,麻章农业对外合作试验区架起农产品出海金桥
- 头条焕亮双眸,遇见“睛”彩!广东郑明明呵护年轻眼周
- 头条校企携手20年耕耘 成就金正大全球缓控释肥引领者
- 头条品牌好物齐亮相 扫码福利抢不停——“品味南皮”年货盛典启幕 打造新春消费盛宴
- 头条以品质,致未来!雪川斩获2025中国消费创新大会“双领军”大奖
- 头条20个月,3大平台,300倍!元育生物以全左旋虾青素引领合成生物新纪元
- 头条现代高标准全域生态种养循环农业宣讲暨项目签约仪式成功举办
- 头条向新提质,向高跃升!天能携共赢商擎启2025!
- 头条向新提质,向高跃升!天能携共赢商擎启2025!
- 头条天能电池六大动力科技,重塑引擎新动力,定义电池新境界!


